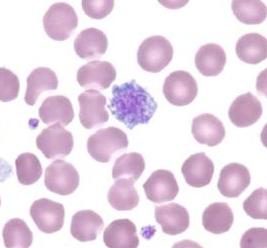
моноциты понижены

Моноциты представляют собой группу клеток, относящихся к лейкоцитам. Они отвечают за иммунную систему человека и выполняют несколько очень важных функций — противостоят развитию инфекций, борются с паразитарными микроорганизмами, опухолевыми образованиями, а также растворяют сгустки крови.
Моноциты представляют собой группу клеток, относящихся к лейкоцитам. Они отвечают за иммунную систему человека и выполняют несколько очень важных функций — противостоят развитию инфекций, борются с паразитарными микроорганизмами, опухолевыми образованиями, а также растворяют сгустки крови.
Эти клетки очень сильно влияют и на лимфоциты, а это значит и на всю систему кроветворения.
Обычно моноциты, норма которых составляет 4-8%, смещаются в сторону повышения. Впрочем, бывают ситуации, при которых количество этих клеток снижается, хотя низкие моноциты в крови — явление несколько более редкое, нежели изменения противоположного характера.
Это не обязательно свидетельствует о каком-то заболевании, но в большинстве случаев низкие моноциты, к сожалению, говорят о патологическом процессе. Ниже мы более подробно рассмотрим, о чем это говорит, и какие причины способствуют этому.
Норма содержания моноцитов в крови
У здорового взрослого человека и у детей старше 13 лет в норме количество моноцитов в крови составляет от 3 до 11% от количества всех лейкоцитов или от 0,1 до 0,6 х 109/л.
Моноциты в крови у детей до 13 лет составляют от 2 до 12% от общего количества лейкоцитов.
Роль моноцитов в организме
Основной функций моноцитов является поглощение отмерших тканей и активная борьба с паразитами, микробами и опухолями. Они стоят на страже чистоты крови и участвуют в её обновлении, недаром их называют «дворниками организма».
Поэтому в организме моноцитов играют важную роль, в первую очередь это:
- защита организма от микробной инфекции;
- регенерация тканей;
- противоопухолевая защита;
- фагоцитоз поврежденных и отмерших клеток тканей;
- токсическое воздействие на паразитов, попадающих в организм человека.
Продолжительность жизни этих кровяных телец составляет всего лишь 3 суток, после чего происходит их проникновение в ткани, где они трансформируются в тканевые макрофаги. Одной из важнейших функций этого элемента считается их явно выраженные противоопухолевые свойства. Кроме этого они отвечают и за выработку интерферона.

Причины пониженных моноцитов у взрослых
Если в крови у взрослого по каким-либо причинам происходит понижение моноцитов, то это значит, что может наступить монопения. Данная патология очень часто наблюдается у беременных женщин сразу после родов. Кроме этого есть ряд и других причин, которые могут привести к снижению моноцитов, как у взрослых, так и у детей. Следует отметить, что при снижении этого элемента в крови автоматически происходит уменьшение и других лейкоцитов.
Теперь более подробно рассмотрим, о чем говорит пониженный уровень моноцитов у взрослого человека. Итак, причины тут могут быть следующие:
- шок, стресс;
- хирургическое вмешательство;
- воздействие ионизирующего излучения;
- химическое отравление;
- апластическая анемия;
- истощение организма в целом;
- тяжелые гнойные болезни;
- длительный прием глюкокортикостероидных препаратов;
- серьезное инфекционное заболевание с понижением нейтрофилов, например, брюшной тиф;
- поражение костного мозга (так как моноциты формируются именно в нем, а уже потом попадают в кровь).
Если общий анализ крови показал низкое содержание моноцитов, то необходимо обратиться к врачу, чтобы предотвратить прогрессирование болезни. Лечение моноцитопении — это устранение причин, вызвавших данный симптом. В каждом случае перечень мероприятий по их аннулированию различен. Иногда достаточно пересмотреть диету, чтобы повысить количество клеток до нужного уровня. В некоторых случаях потребуется прием специальных препаратов и хирургическое вмешательство.
Пониженные моноциты у ребенка
Причины развития моноцитопении у детей такие же, как и у взрослых. К ним относятся следующие патологии:
- острые инфекционные заболевания;
- поражения костного мозга;
- оперативное вмешательство;
- гнойные воспалительные процессы в организме;
- сепсис;
- истощение организма.
Пониженное содержание моноцитов в крови у детей наблюдается гораздо чаще, чем высокое. Поскольку норма моноцитов у ребенка варьируется в зависимости от возраста, то и величина отклонения от нормы, при которой можно говорить о моноцитопении, различна для разных возрастных групп.
Что делать при низких моноцитах
Основная терапия при пониженных моноцитах направлена на ликвидацию первопричин, которые привели к их снижению. Каждый конкретный случай индивидуален, и врач может как назначить медикаментозное лечение, так и полностью отменить имеющееся (которое и послужило причиной снижения моноцитов в крови).
Как правило, больному рекомендуется определённая диета. В некоторых отдельных случаях при пониженных показателях моноцитов может потребоваться помощь хирурга.

